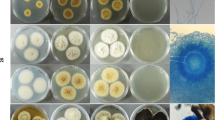

Abstract
Washing machines are commonly used in households and are considered indispensable appliances for maintaining cleanliness and hygiene. Environmental conditions within household washing machines are ideal for fungal colonization, which may pose risks to human health and contribute to sick building syndrome. This study aimed to investigate the fungal species contamination in the building washing machines. A total of 50 building washing machines were swab-sampled at three locations: the detergent drawer, the inner and outer parts of the rubber door seal. The housekeeping conditions of these appliances were assessed through a questionnaire. The isolated fungi were identified using standard mycological diagnostic procedures and molecular analysis based on the ITS1/ITS4 and β-tubulin gene regions. The possibility of fungal agents transferring from contaminated washing machines to autoclaved clothes during laundry cycles was investigated. Fungi were detected in 82% of the sampled appliances, with the inner rubber door seal being the most frequently colonized area. Using conventional and molecular techniques, we identified 122 fungal isolates, encompassing 17 diverse genera of molds, yeast-like, and yeast fungi. The mold fungi included 14 genera of hyaline and black genus. Among these, the most frequently identified genera of hyaline and black fungi were Aspergillus (27.7%), and Cladosporium (10.7%), respectively. This study demonstrates that building washing machines may serve as suitable ecological niches for fungal growth and transmission. Therefore, regular cleaning and disinfection of these devices are necessary.
Similar content being viewed by others
Introduction
The microbial content of airborne particles, both indoors and outdoors, is of paramount concern from both environmental and public health perspectives. Sick building syndrome (SBS) is a term used to describe a condition in which occupants of a building experience illness symptoms due to indoor air pollution1. Variable SBS symptoms encompass headaches, vertigo, irritation of the eyes, nose, and esophagus, and as well as respiratory complications. One potential source of indoor air pollution contributing to SBS is fungal contamination. Fungi have the potential to adversely affect health and well-being, particularly through the allergenicity of fungal elements and the presence of toxic secondary metabolites2,3,4,5. Numerous fungal species can colonize indoor environments within buildings, including walls, furniture, and household appliances such as washing machines (WMs) and dishwashers, subsequently producing spores and volatile organic metabolites5. These building WMs, commonly found in laundry facilities in buildings, are an area of interest due to their potential as a niche for the growth and dissemination of fungi. These fungal spores and microbial compounds can lead to irritation, respiratory illnesses, cytotoxicity, fatigue, allergic reactions, asthma, and infections, especially in immunocompromised individuals6,7.
Fungi can colonize both visible and hidden areas of WMs under favorable micro-environmental conditions, such as reduced washing temperatures, moisture, and the use of biodegradable detergents, leading to fungal enrichment and biofilm formation8,9. Importantly, microbial biofilms may serve as reservoirs of pathogenic microorganisms that can contaminate laundry, potentially endangering the health of susceptible individuals. Previous research has demonstrated that WMs can be colonized by a wide variety of microorganisms and often develop biofilm structures on their surfaces10. Using molecular methods, Nix et al.11 investigated microorganisms at various sites within WMs and identified representatives of the Basidiomycota and Ascomycota as the predominant fungal colonizers in these appliances.
In the context of household appliances, previous studies have emphasized the importance of cleaning performance and energy efficiency during laundering processes, with less emphasis on the hygienic impact of WMs4,9,12. Several studies have suggested that fabrics and textiles can play a role in the transmission of infections, demonstrating the potential for microbial respiratory infection spread associated with WM usage during laundering1,2,12. Fungi residing in WMs can potentially disseminate into the kitchen or any environment where the WM is located through aerosols, wastewater, and direct contact between contaminated WMs and users’ hands7,13.
Furthermore, there is evidence linking fungal contamination in WMs to indoor air pollution, which has been associated with SBS. Consequently, WMs may serve as a source of environmental fungal contamination and its associated effects14,15. The favorable conditions within WMs, characterized by moisture, humidity, and nutrient-rich environments, promote fungal growth, biodeterioration, and discoloration. These machines are subjected to fluctuating temperature and humidity levels, often harboring residual moisture that can persist over time. Furthermore, the organic materials frequently encountered in WMs, such as lint and detergent residues, can serve as substrates for fungal growth4,9,15. Given these conditions, it is conceivable that fungi could colonize and persist within building WMs, posing potential risks to residents, particularly those with compromised immune systems. As a result, this poses hygiene risks, diminishes the aesthetic appeal of WMs, and shortens their useful lifespan7,11. Current research focuses on detecting emerging fungi in indoor environments, whose diversity and potency may differ from those in natural environments. While these investigations have provided valuable insights into indoor fungal ecology, the unique conditions within WMs have received limited attention. The primary objective of this study was to assess fungal diversity within the specific environment of building WMs, with due consideration of potential risks to users. We also aimed to assess the potential transfer of fungal agents from contaminated washing machines to clean cloths.
Result
Building WMs usage parameters and characterization
In this investigation, we employed a questionnaire to gather data on various usage parameters related to WMs within the studied environment (Table 1). The age range for the 82% of WMs that were positive for fungi growth was 6–10 years. This observation suggests a potential relationship between the age of the machines and the likelihood of fungal contamination. Older machines may develop wear and tear that could create suitable conditions for fungal colonization.
The most commonly observed washing temperature associated with favorable fungal growth was 30°C. This finding is of importance, as different temperatures can impact the survival and growth of fungi. Notably, our study revealed that 31% of the contaminated WMs were situated in kitchens, raising concerns about the presence of fungi in an area crucial for food preparation and hygiene. Additionally, our research highlighted that a significant portion (37%) of contaminated WMs were not subject to a regular cleaning routine. However, as shown in Table 1, our statistical analysis did not find any statistically significant correlations (p-values > 0.05) between fungal growth and the studied variables (p-values > 0.05).
Conventional and molecular identification of fungal isolates
Out of the 50 building WMs tested, 41 (82%) were found to be positive for fungal contamination. The inner parts of the rubber door seals exhibited the highest contamination rate (37.5%), followed by the outer parts of rubber door seals (36.1%), and detergent drawers (26.2%) (Figs. 1 and 2). Among the 122 fungal species isolated, 17 genera of molds, yeast-like fungi, and yeasts were identified. Sequencing revealed that the mold fungi consisted of seven genera of hyaline molds and seven genera of black mold fungi at various species levels (Tables 2 and 3). Notably, Aspergillus spp. (27.7%), Penicillium spp. (11.4%), Fusarium spp. (4.8%), Scopulariopsis spp. (2.4%), Acremonium spp. (1.6%), Mucor spp. (1.6%), and Corallomycetella sp. (0.8%) are listed in Table 2 as the hyaline fungi isolated in this investigation.
(A) (1, 2) & (B) (1, 2): Sampling sites in the WMs. A1, A2, B1, and B2: Primary isolation of different fungi from WMs swab samples. Molecular identification of fungal isolates; A1a: Ochroconis musae, A1b: Rhodotorula spp., A1C: Chaetomium madrasense, A2a: Exophiala mesophila, A2b: Aspergillus flavus, A2c: Scopulariopsis gracilis, B1a: Aspergillus multicolor, B1b: Candida parapsilosis, B1c: Fusarium prolifratum, B2a: Alternaria sorghi, B2b: Penicillium chrysogenum, B2c: Aspergillus terreus.
Table 3 summarizes the identification and quantification of black mold, yeast, and yeast-like species of fungi obtained through conventional and molecular methodologies. The most commonly isolated black mold genus was Cladosporium spp. (10.7%) followed by Ochroconis spp. (9%), which was the second most frequently detected genus in tested building WMs. As depicted in Fig. 3, the ITS and -tubulin regions of extracted DNA were successfully amplified and the generated sequences from this study have been deposited in the GenBank database.
Representative agarose gel electrophoresis of PCR products Lane 1: Cladosporium halatolerans; Lane 2: Alternaria porri; Lanes 3–6: Ochroconis musae; Lanes 7: Ochroconis constricta; Lane 8: Exophiala mesophila; Lane 9: positive control; Lane 10: negative control (D.W.); and Lane M is the 100-bp molecular size marker.
The potential for fungal agents to transfer from contaminated WMs to autoclaved socks
This investigation aimed to explore whether fungal agents, originally harbored within WMs that were previously identified as contaminated, could be transferred to sterilized socks during the washing process. Remarkably, all ten of the autoclaved socks used in this study (n = 10, 100%) tested positive for fungal culture following their laundering in the contaminated WMs. This unequivocal finding underscores the capacity of fungal agents to not only survive within the WM environment but also to contaminate laundered textiles.
Furthermore, it is noteworthy that the fungal species recovered from the laundered socks exhibited a significant degree of similarity (70% of the time) to those previously isolated from the contaminated WMs.
Discussion
In the present day, people spend a significant amount of their time inside buildings, whether it's in their homes, offices, schools, or other establishments. The cleanliness and sanitation of these buildings are paramount for maintaining the health and well-being of individuals. Washing machines are essential appliances that provide an ideal environment for microbial growth4,8. They provide a warm and moist environment, which can promote the growth of microbes such as bacteria and fungi. Additionally, residues from detergents and fabric softeners used in WMs can accumulate on various surfaces, including the drum, seals, and detergent drawers. These residues may contain organic matter that serves as a nutrient source for microbes, facilitating their growth. However, when a machine remains unused for extended periods without proper cleaning or maintenance, it becomes susceptible to microbial colonization7. Another crucial concern is cross-contamination. If contaminated items, such as soiled clothes or towels with visible dirt, are placed inside WMs, potentially harmful microorganisms can enter the WM's environment, leading to further microbial growth9,10.
The primary focus of this study was to assess the potential of building WMs as suitable environments for the growth and proliferation of fungi. Remarkably, we observed a high prevalence (82%) of fungal contamination in these WMs, with a wide array of fungal species identified. Among the various components of WMs examined, the inner rubber door seal was found to be the most frequently colonized area, indicating a preference for fungi to thrive in this specific region. This susceptibility can be attributed to a combination of factors. Firstly, its proximity to the WM drum and the extensive use of water during washing and rinsing cycles create a moist and damp environment, which is conducive to fungal growth, including molds and yeasts. Over time, the accumulation of residues from detergents, fabric softeners, and organic matter within the seal's folds provides essential nutrients for fungi. The generation of heat during machine operation, coupled with moisture from the washing process, establishes favorable temperature conditions for fungal proliferation. Additionally, the limited air circulation within this enclosed space contributes to moisture retention, further promoting fungal growth, as fungi tend to flourish in environments with reduced airflow. The porous nature of the rubber seal offers additional surfaces for fungi to attach and form biofilms, rendering them resistant to removal. Furthermore, the seal's direct contact with laundry items, which may carry fungal contaminants, can lead to the easy transfer of fungal agents onto the seal during washing, introducing fungi into the WM's environment. Lastly, the inner rubber door seal often receives less cleaning attention compared to more visible machine parts, allowing fungal growth to persist and potentially thrive.
Among the isolated fungi, mold fungi (80.3%) were predominant, outnumbering yeast (19.7%) strains. Notably, Aspergillus species (27.7%) were the most frequently isolated fungi in this study, followed by Penicillium genus (11.4%), and the Cladosporium genus (10.7%). Additionally, yeast strains including the Rhodotorula genus (12.3%), Candida parapsilosis (4.8%), and also C. orthopsilosis, and C. lusitania (each at 0.8%) were identified. These findings are consistent with previous studies that have highlighted the potential for fungal growth and colonization in damp and humid environments16. For example, in the 2019 study by Tischner et al.7 which involved 61 WMs, 71 positive cultures were isolated, with mold fungi isolates (55%) being more common than yeast isolates (45%), aligning with our study. In the present study, most of the genera and species of fungal agents isolated from WMs are similar to those in other studies. However, due to the influence of various cultural and environmental factors, as well as climatic differences in each geographical region, the percentage of fungal agents isolated in these studies is variable. Our findings strongly suggest a potential health risk associated with fungal contamination in building WMs. Pathogenic fungi have been linked to various respiratory and allergic diseases, contributing to what is commonly referred to as Sick Building Syndrome (SBS), particularly in individuals with compromised immune systems. Consequently, individuals who frequently use WMs may face an increased risk of exposure to potentially harmful fungi5.
In this study, the most commonly isolated genus contaminating WMs was Aspergillus spp. In contrast, Tischner et al. found that, the Penicillium genus was the most common hyalohyphomycete genus in their study7. The Aspergillus genus is an opportunistic saprophyte with numerous species and its spores are abundant in our surroundings. It is associated with a wide range of clinical manifestations in various parts of the body, including asthma, allergic bronchopulmonary diseases, eye and sinus infections, onychomycosis, aspergilloma, chronic pulmonary aspergillosis, and diseases related to the central nervous system17,18. In this study, A. flavus complex, A. fumigatus complex, A. niger complex, A. terreus complex, A. montevidensis, A. tubingensis, A. calidoustus, A. sydowii, A. multicolor, A. protuberus were isolated. All of these species have the potential to cause diseases in susceptible hosts. Different species of this genus have different inherent drug sensitivity. For instance, A. terreus is typically resistant to amphotericin B. Also, A. calidoustus species are known to be resistant to both amphotericin B and voriconazole. Notably, both A. terreus and A. calidoustus were among the isolates in our study19. The genus Penicillium is an opportunistic saprophyte that is abundant in building environments and produces secondary metabolites including mycotoxins that can contribute to allergic reactions. In this study, we identified P. chrysogenum, a species known for its ability to produce various allergenic metabolites. In some instances, this species has been identified as the causative agent of the invasive disease20. The genus Fusarium is a common soil saprophyte and a plant pathogen known for its capacity to produce mycotoxins21. In this study, we isolated F. prolifratum, which has been reported as a pathogenic species22. Fusarium solani is the most common infection-causing species of this genus, which was isolated from WMs in this study. Additionally, we identified a group of fungi in this study referred to as black fungi (19.7%). These fungi are characterized by their visible dark pigmentation on plates, attributed to melanin, and were confirmed through molecular sequencing methods. The black fungi isolated in this study have the potential to cause subcutaneous phaeohyphomycosis diseases, particularly in individuals with compromised immune systems23,24. Within the black fungus group, the genus Ochroconis (9%) was the most commonly isolated. Ochroconis species exhibit heat tolerance and can withstand temperatures up to 45 °C. Some species within this genus, such as O. mirabilis and O. musae have been known to cause subcutaneous and systemic diseases, particularly affecting the lungs and brain, in individuals with immune system deficiencies25,26,27. Furthermore, among the studied WMs, we isolated the C. parpsilosis complex (5.6%). This complex of Candida species is known to colonize the surfaces of sanitary equipment, including WMs, dishwashers, and water distribution systems. The C.parapsilosis species complex, which includes C. parapsilosis sensu stricto, C. metapsilosis, and C. orthopsilosis, is considered a significant hospital opportunists and ranks as the second most common cause of mycosis in immunocompromised patients28. Some microorganisms exhibit superior survival capabilities in challenging environments, such as WMs compared to others. Notably, specific bacteria like Staphylococcus aureus and fungi like Candida species can persist even in the presence of detergents and high water temperatures. These microorganisms also possess the ability to form biofilms, which can facilitate their entry into the host, particularly through prosthetic materials. This species shows more resistance to antifungal drugs. For instance, Candida species, such as C. glabrata, demonstrate significantly higher resistance to fluconazole, a commonly used antifungal medication, with resistance levels approximately five times higher than those observed in C. albicans28. In another study that can only detect yeast species, the most yeast isolated from investigated WMs were Rhodotrula genus (66.7%) and C. parapsilosis (25.3%)29. Previous studies have demonstrated that the transfer of fungal species from WMs to clothes can potentially lead to diseases and skin problems28,30.
In our present study, we also found evidence supporting the transfer of fungal contamination from WMs to clothes during the washing process. It is pertinent to highlight that the fungal species identified in the laundered socks bore a substantial resemblance, accounting for 70% of cases, to those previously isolated from the contaminated washing machines (WMs). This suggests a potential link between the fungal populations present in the WM's interior and those colonizing laundered items, in this case, socks. Such a connection raises critical questions regarding the mechanisms and pathways through which these fungal agents traverse from the machine to textiles and underscores the need for further investigation into this phenomenon. The findings of this study carry profound implications for hygiene practices, especially within communal laundry facilities where multiple users may unknowingly share potentially contaminated machines. These microorganisms can be transferred from WMs to clothes through various mechanisms, including direct contact with the interior surfaces of the WMs, aerosolization, and waterborne transfer5,7,13.
Our findings emphasize the critical need for regular cleaning and disinfection of building WMs. Establishing proper cleaning protocols is essential to eliminate any accumulated dirt or organic matter that can serve as a nutrient source for fungal growth6. Additionally, the use of effective disinfectants against fungi is crucial to eradicate any residual spores or hyphae. To minimize fungal contamination, it is essential to implement appropriate practices such as leaving the WM door open after use to allow for air circulation and using dedicated WM cleaners designed to remove microbial agents. However, further research is warranted to comprehensively assess the extent of the risk posed by these contaminated machines and to develop appropriate preventive measures4,9. In conclusion, while the study provides valuable insights into fungal contamination in household WMs, it is essential to acknowledge the limitations related to sample size, restricted geographical location, and potential confounding factors such as cultural, architectural, and economic variables. Addressing these limitations in future research efforts can contribute to a more comprehensive and nuanced understanding of fungal contamination in WM across diverse settings.
Conclusion
The study highlights the widespread fungal contamination in building washing machines (WMs), with the inner rubber door seal being the most commonly affected area. Fungal agents can transfer from contaminated WMs to laundered textiles, posing potential health risks. Regular cleaning and disinfection of WMs are essential to mitigate this issue. The most frequently identified fungal genera were Aspergillus and Cladosporium, known to cause health problems, especially in immunocompromised individuals. Enhanced hygiene practices in communal laundry facilities are crucial. Further research is needed to develop effective preventive measures.
Method and material
Study design
We designed a self-administered questionnaire to assess various usage parameters of the WMs, including user habits, housekeeping conditions, current pigmentation, and the presence and quantity of fungal species. We then distributed these questionnaires and proceeded with WM sampling and device evaluation based on the level of contamination, followed by species identification. The samples were collected from the most contaminated surfaces, as determined by visual assessment, including both the inner and outer parts of the rubber door seal and the detergent drawer. It's noteworthy that all methods described in this study strictly adhered to relevant guidelines and regulations. Additionally, the experimental protocols employed in this study received approval from the Vice-Chancellor for Research of Shiraz University of Medical Sciences. Informed consent was obtained from all participants or their legal guardians prior to their involvement in the study. The whole steps of this investigation are illustrated in Fig. 4.
Building WMs sampling
Swab samples were collected from 50 household WMs in Shiraz, Iran, during the year 2022. The WMs were sampled at the 3 sites including, the inner and outer parts of the rubber door seal and detergent drawer. These areas are known to be prone to moisture retention and organic residue buildup, creating conditions conducive to fungal growth. The detergent drawer, for instance, can accumulate detergent and fabric softener residues, while the rubber door seal can trap moisture and residues from previous wash cycles. These factors make these sites likely locations for fungal colonization. Mentioned sites of WMs were swapped with pre-moistened sterile cotton swabs in sterile physiological saline (0.9%). The sampling area was ~ 40 cm2 for the detergent drawer, ~ 25 cm2, and ~ 45 cm2 for the rubber door seal, respectively. After that, the swab was transferred to a sterile tube with 2 mL of sterile physiological saline (0.9%) and transported to the medical mycology laboratory. All samples were analyzed within 1 h after sampling7,8.
Fungal isolation and identification of fungi recovered from WMs
Samples from each WMs were inoculated onto two sabouraud dextrose agar (SDA) media containing (0.05%) chloramphenicol and incubated at 32 °C and 25 °C which were monitored for 2 weeks. After the samples were cultured, the pure cultures of the fungi were isolated and stored for further evaluation7. The identification of isolated molds and yeasts was based on the morphological (macroscopic-microscopic) features and molecular technique according to sequence analyses.
Morphological identification of fungi
The gross identification of mold and yeast fungi was performed using mycological laboratory-approved procedures. The development colonies were evaluated for their macroscopic characteristics on SDA, which included the pigment of the colony's surface and underside, shape, structure, and consistency. Subsequently, microscopic features such as size, shape, and blastospores arrangement, produce pseudohyphae or chlamydospores were assessed by using teas mounts and slide culture methods (Fig. 5)2.
Molecular identification
DNA extraction of yeast
Genomic DNA extraction was performed from purified yeast cultures by using the boiling method described by Makimura et al.31. Briefly, a small amount of the yeast colony was suspended in 100 µL of lysis buffer (100 mM Tris–HCl, 0.5% sodium dodecyl sulfate (SDS), and 30 mM ethylene diamine tetra acetic acid (EDTA)) and then boiled for 15 min at 100 °C. Therefore potassium acetate solution (2.5 M) was added and kept in an ice box for 1 h. Then it was removed from the cold chain and centrifuged (16,125×g for 5 min), and the supernatant was transferred to a new tube. The extracted DNA in the supernatant was washed with ethanol, dried under sterile conditions, and re-suspended in 50 µL of distilled water (DW) for further usage32.
DNA extraction of mold
Total genomic DNA was extracted from mold fungi by the rapid preparation method. The small portion of mycelium and conidia were grown on SDA at 25 °C, was inoculated to a 500 µl of lysis buffer (400 mM Tris–HCl [pH = 8], 60 mM EDTA pH [pH = 8], 150 mM NaCl, 1% [w/v] SDS), using a sterile applicator for mycelium disruption. After 10 min at room temperature, adding 150 µl of potassium acetate buffer pH [pH = 4.8] (5 M potassium acetate, acetic acid), to remove cell debris, centrifugation was performed) > 10,000g for 1 min (. The supernatant solution was transferred to a new tube, centrifuged, and an equal volume of isopropyl alcohol was added. Then, the tube was centrifuged (> 10,000g for 2 min), and the supernatant was discarded. The DNA pellet was washed and centrifuged with ethanol (70% (v/v)), then the supernatant was discarded. The air-dried pellet of DNA dissolved in 50 µl of DW and stored at freezer − 20 °C before use33.
Amplification and sequencing of the ITS region
Yeast species identification was amplified using an internal transcribed spacer (ITS) region with primers ITS1 (5′-TCCGTAGGTGAACCTGCGG-3′) and ITS4 (5′-TCCTCCGCTTATTGATATGC-3′). The PCR amplification was carried out in a final volume of 50 μL containing 5 μL of PCR buffer, 1.5 mM MgCl2, 0.8 mM deoxynucleoside triphosphates (dNTPs, 0.2 mM each), 1.2 U of Taq DNA polymerase (Roche, Mannheim, Germany), 0.5 μM of each primer, 5 µL of DNA template, and finally DW. An initial denaturation step at 94 °C for 4 min was followed by 35 cycles of denaturation at 94 °C for 45s, annealing at 64 °C for 1 min, and extending at 72 °C for 1 min. The PCR procedure was followed by agarose gel electrophoresis (1.0%) and stained with ethidium bromide (EB). Then, amplified PCR products were purified and sequenced (Bioneer Company, South Korea). Basic Local Alignment Search Tool (BLAST) was used for comparison with reference patterns in the NCBI/GeneBank database29,34.
Amplification and sequencing of the β-tubulin regions
The PCR of the genomic DNA product of mold fungi was characterized according to a standard PCR protocol. A fragment of the β-tubulin (βt.) gene was amplified using the primers βt.1 (5′ GGT AAC CAA ATC GGT GCT GCT TTC -3′) and βt.2 (5′- ACC CTC AGT GTA GTG ACC CTT GGC -3′) following the Glass and Donaldson study (20). The PCR amplification was performed in a final volume of 50 μL containing 5 μL of PCR buffer, 1 mM of MgCl2, 2.5 mM dNTPs (0.2 mM each), 1.2 U of Taq DNA polymerase (Roche, Mannheim, Germany), 20 ρM each of the primers, 5 µL of DNA template, and eventually, with DW, a final volume (50 µL). An initial denaturing at 94 °C for 5 min was followed by 32 cycles of denaturation at 92 °C for 45 s, annealing at 54 °C for 45 s, and final extension at 72 °C for 1 min. The PCR products were separated on a 1% agarose gel and stained with EB (21, 22). Then, the PCR products were sequenced and analyzed using the Basic Local Alignment Search Tool (BLAST) and matched with sequences in the NCBI/GeneBank data.
Investigating the possibility of transferring fungal agents from contaminated WMs to autoclaved socks
In the following, the fungal agents transferring from contaminated WMs to the 10 pairs of autoclaved socks during the washing process are examined. According to Fig. 2, after the washing process in the contaminated WMs, washed socks were transferred to the medical mycology laboratory. In the sterile condition under the laminar airflow, the washed socks from the contaminated WMs were transferred to the glass bottle containing 10 ml of sterile DW and 500 ml of Tween 80. After 30 min, the soaking socks were removed from the glass bottle, and the remaining solution was filtered with a sterile membrane filter (0.45 μm, Merck, Millipore) and vacuum pump. After passing the entire solution through the filtration device, the filter is separated and placed on SDA plates, which were incubated at 32 °C and 25 °C for up to 7 days. The growth colonies were evaluated, and mycological identification was documented35.
Statistical analyses
The statistical analysis was performed using SPSS (version 20) software for checking the statistical significance between the fungi growth and sampling sites of building WMs which p-values < 0.05 were considered statistically significant.
Data availability
The datasets used and/or analyzed during the current study are available from the corresponding author on reasonable request.
References
Wang, M. et al. Building and health: Mapping the knowledge development of sick building syndrome. Buildings 12(3), 287 (2022).
Rawson, T. M., Fatania, N. & Abdolrasouli, A. UK standards for microbiology investigations of ear infection (SMI B1) are inadequate for the recovery of fungal pathogens and laboratory diagnosis of otomycosis: A real-life prospective evaluation. Mycoses 65(4), 490–495 (2022).
Yamada, Y. et al. Comparison of different methods for extraction of mitochondrial DNA from human pathogenic yeasts. Jpn. J. Infect. Dis. 55(4), 122–125 (2002).
Adeoyo, O. R. & Omolola, O. G. Evaluation of indoor and outdoor fungal flora of two poultry farms in Akungba-Akoko and Ayegunle-Akoko. Saudi J. Biomed. Res. 7(3), 114–118 (2022).
Sarkhosh, M. et al. Indoor air quality associations with sick building syndrome: An application of decision tree technology. Build. Environ. 188, 107446 (2021).
Elsheikh, E. G. et al. Detection of fungal contamination of ward furnishing and medical equipment used in intensive care unit and neonatal intensive care unit. J. Drug Deliv. Ther. 13(3), 47–50 (2023).
Tischner, Z. et al. Environmental characteristics and taxonomy of microscopic fungi isolated from washing machines. Fungal Biol. 123(9), 650–659 (2019).
Döğen, A. et al. Candida parapsilosis in domestic laundry machines. Med. Mycol. 55(8), 813–819 (2017).
Whitehead, K. et al. Potential for microbial cross contamination of laundry from public washing machines. Microbiol. Res. 13(4), 995–1006 (2022).
Pintong, L. et al. Isolation of prominent opportunistic yeasts, Candida spp., from coin-operated washing machines. J. Microbiol. Biotechnol. Food Sci. 12, e5592–e5592 (2023).
Nix, I. D., Frontzek, A. & Bockmühl, D. P. Characterization of microbial communities in household washing machines. Tenside Surfactants Deterg. 52(6), 432–440 (2015).
Jacksch, S. et al. Cultivation-based quantification and identification of bacteria at two hygienic key sides of domestic washing machines. Microorganisms 9(5), 905 (2021).
Zupančič, J. et al. The black yeast Exophiala dermatitidis and other selected opportunistic human fungal pathogens spread from dishwashers to kitchens. PLoS ONE 11(2), e0148166 (2016).
Prenafeta-Boldú, F. X., Medina-Armijo, C. & Isola, D., Black fungi in the built environment—the good, the bad, and the ugly. In Viruses, bacteria and fungi in the built environment 65–99. Elsevier (2022)
Isola, D. et al. Isolation and screening of black fungi as degraders of volatile aromatic hydrocarbons. Mycopathologia 175, 369–379 (2013).
Badali, H. et al. Cladophialophora saturnica sp. nov., a new opportunistic species of Chaetothyriales revealed using molecular data. Med. Mycol. 47(1), 51–66 (2009).
Zareshahrabadi, Z. et al. COVID-19-associated facial cutaneous mucormycosis superinfection: A potentially life-threatening disease. Clin. Case Rep. 10(7), e6103 (2022).
Richardson, M. & Rautemaa-Richardson, R. Exposure to Aspergillus in home and healthcare facilities’ water environments: Focus on biofilms. Microorganisms 7(1), 7 (2019).
George R. Thompson I, M.D.a.J.-A.H.Y., M.D., Aspergillus infections. N. Engl. J. Med. 2021. 385: 1496–1509.
Reboux, G., Rocchi, S., Vacheyrou, M. & Millon, L. Identifying indoor air Penicillium species: a challenge for allergic patients. J. Med. Microbiol. 65, 812–821 (2019).
Ma, L.-J. et al. Fusarium pathogenomics. Ann. Rev. Microbiol. 67, 399–416 (2013).
Alavi Darazam, I. et al. Meningoencephalitis caused by Fusarium proliferatum: An unusual case. Oncogenesis 50, 1023–1027 (2022).
Hashimoto, K., Fujii, H. & Kawakami, Y. Genetic identification of dematiaceous fungi isolated from washing machine in Japan, and considering of fungal removal methods. Biocontrol Sci. 24(2), 89–96 (2019).
Kwan, S. et al. The impact of ventilation rate on the fungal and bacterial ecology of home indoor air. Build. Environ. 177, 106800 (2020).
De la Rosa, J. M. et al. Structure of melanins from the fungi Ochroconis lascauxensis and Ochroconis anomala contaminating rock art in the Lascaux Cave. Sci. Rep. 7(1), 1–11 (2017).
Yazdanparast, S. et al. Consistent high prevalence of Exophiala dermatitidis, a neurotropic opportunist, on railway sleepers. J. de Mycol. Méd. 27(2), 180–187 (2017).
De Hoog, G. et al. Waterborne Exophiala species causing disease in cold-blooded animals. Persoonia-Mol. Phylogeny Evol. Fungi 27(1), 46–72 (2011).
Arastehfar, A. et al. Evaluation of molecular epidemiology, clinical characteristics, antifungal susceptibility profiles, and molecular mechanisms of antifungal resistance of Iranian Candida parapsilosis species complex blood isolates. Front. Cell. Infect. Microbiol. 10, 206 (2020).
Dogen, A. et al. Candida parapsilosis in domestic laundry machines. Med. Mycol. 55, 813–819 (2017).
Duplan, P., Memon, M. B., Choudhry, H., Patterson, J. A rare case of Candida parapsilosis lumbar discitis with osteomyelitis. Cureus 14(6), e25955 (2022).
Makimura, K., Murayama, S. Y. & Yamaguchi, H. Detection of a wide range of medically important fungi by the polymerase chain reaction. J. Med. Microbiol. 40, 358–364 (1994).
Yamada, Y. et al. Comparison of different methods for extraction of mitochondrial DNA from human pathogenic yeasts. Jpn. J. Infect. Dis. 55, 122–125 (2002).
Liu, D., Coloe, S., Baird, R. & Pedersen, J. Rapid mini-preparation of fungal DNA for PCR. J. Clin. Mirobiol. 38, 471 (2000).
Tischner, Z. et al. Environmental characteristics and taxonomy of microscopic fungi isolated from washing machines. Fungal Biol. 123, 650–659 (2019).
Amichai, B. et al. The effect of domestic laundry processes on fungal contamination of socks. Int. J. Dermatol. 52(11), 1392–1394 (2013).
Acknowledgements
This study is part of MSc thesis of, Neda Amirzadeh [Grant No. 22712] and financially supported by Shiraz University of Medical Sciences. This research was financially supported by the Vice-Chancellor for Research of Shiraz University of Medical Sciences (Grant No. 22712).
Author information
Authors and Affiliations
Contributions
Conceptualization, K.Z.; methodology, Z.Z., R.N. and N.A.; formal analysis, K.Z. and R.M. investigation, K.P. and N.A.; resources, Z.Z. and K.Z.; writing original draft preparation, Z.Z.; writing review and editing, K.Z.; All authors have read and agreed to the published version of the manuscript.
Corresponding author
Ethics declarations
Competing interests
The authors declare no competing interests.
Additional information
Publisher's note
Springer Nature remains neutral with regard to jurisdictional claims in published maps and institutional affiliations.
Rights and permissions
Open Access This article is licensed under a Creative Commons Attribution 4.0 International License, which permits use, sharing, adaptation, distribution and reproduction in any medium or format, as long as you give appropriate credit to the original author(s) and the source, provide a link to the Creative Commons licence, and indicate if changes were made. The images or other third party material in this article are included in the article's Creative Commons licence, unless indicated otherwise in a credit line to the material. If material is not included in the article's Creative Commons licence and your intended use is not permitted by statutory regulation or exceeds the permitted use, you will need to obtain permission directly from the copyright holder. To view a copy of this licence, visit http://creativecommons.org/licenses/by/4.0/.
About this article
Cite this article
Zareshahrabadi, Z., Amirzadeh, N., Pakshir, K. et al. Evaluation of building washing machines as an extreme environment for potentially pathogenic fungi. Sci Rep 13, 21408 (2023). https://doi.org/10.1038/s41598-023-48598-0
Received:
Accepted:
Published:
DOI: https://doi.org/10.1038/s41598-023-48598-0